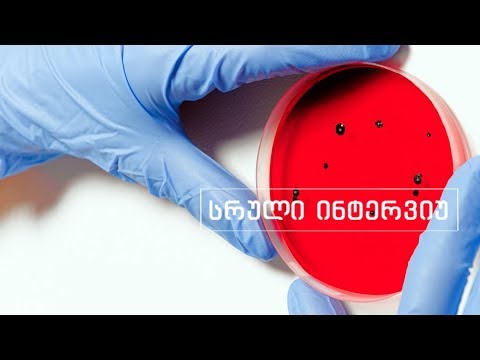
სხვა მხარე კორონა ვირუსის საფრთხეებსა და თავდაცვაზე

კორონა ვირუსი | ნიღბები რომლითაც თავს იცავენ ვუჰანის მოსახლეობა | ვირუსისგან დაცვა
29.02.2020
02:43
კორონა ვირუსი | ვუჰანში პირბადეების დეფიციტის გამო მოსახლეობა სხვადასხვა გზით იცავს თავს კორონავირუსისაგან. #კორონავირუსი #კორონა #პირბადე #ვირუსი #coronavirus #corona #wuhan

მსგავსი ვიდეოები

რით დავკავდეთ კარანტინში | კორონა ვირუსი
Mariam Tsilosani

სამსახური დავკარგე | კორონა ვირუსი
Natela

კორონა ვირუსის გავლენა ქართულ ეკონომიკასა და განათლებაზე
studio13 tbstudio13

საღმრთო ლიტურღია | ქადაგება 15.03.2020
მამა თეოდორე გიგნაძის ქადაგებები / Father Theodore

Mukbang / მუკბანგი | Pipes Joint Burger | ბურგერი | როგორ და...
Mr.Typical Couple
სხვა მხარე კორონა ვირუსის საფრთხეებსა და თავდაცვაზე
studio13 tbstudio13

რამდენ დღეს ძლებს კორონა ვირუსი ზედაპირზე?|GKF|Kartuli|Georg...
იცოდით?

ღამის შოუ | გადაცემა სრულად | 20 მარტი
TV IMEDI



